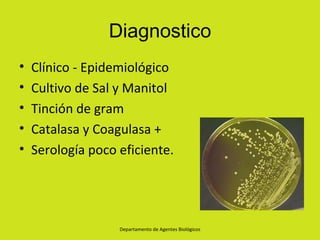
Diagnostico
•   Clínico - Epidemiológico
•   Cultivo de Sal y Manitol
•   Tinción de gram
•   Catalasa y Coagulasa +
•   Serología poco eficiente.




                   Departamento de Agentes Biológicos

Staphylococcus aureus es un agente bacteriano común que causa una amplia gama de infecciones, desde leves hasta potencialmente mortales. Es un coco grampositivo que se transmite entre personas y coloniza la piel y mucosas. Produce diversas toxinas que causan enfermedades como neumonías, intoxicaciones alimentarias, shock tóxico y otras infecciones. Su diagnóstico se realiza mediante cultivos bacteriológicos e identificación bioquímica, y su tratamiento depende del tipo y gravedad de la infección.